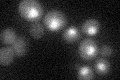
YDR482C
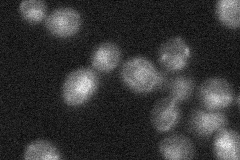
YDR482C
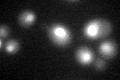
YDR482C
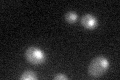
YDR482C

View description
Component of a complex containing Cef1p, putatively involved in pre-mRNA splicing; may bind RNA; has similarity to S. pombe Cwf21p
Localization:
Intensity:
Fold change:
Significance:
-
C’ GFP library in SD
nucleus27.67 -
N' NOP1pr-GFP in SD

nucleus92.4809 -
N' TEF2pr-mCherry in SD

nucleus115.373 -
N' NATIVEpr-GFP in SD
nucleus25.7348 -
N' TEF2pr-VC and Cyto-VN in SD

#N/A0 -
C’ GFP library in SD+DTT
nucleus38.391.38Yes -
C’ GFP library in SD+H2O2

nucleus22.540.81No -
C’ GFP library in Starvation Media
nucleus40.031.44Yes -
C’ GFP library on the background of Pup2-DaMP

nucleus -
C’ GFP library on the background of CCT mutant

nucleus18.09410.653788Yes
